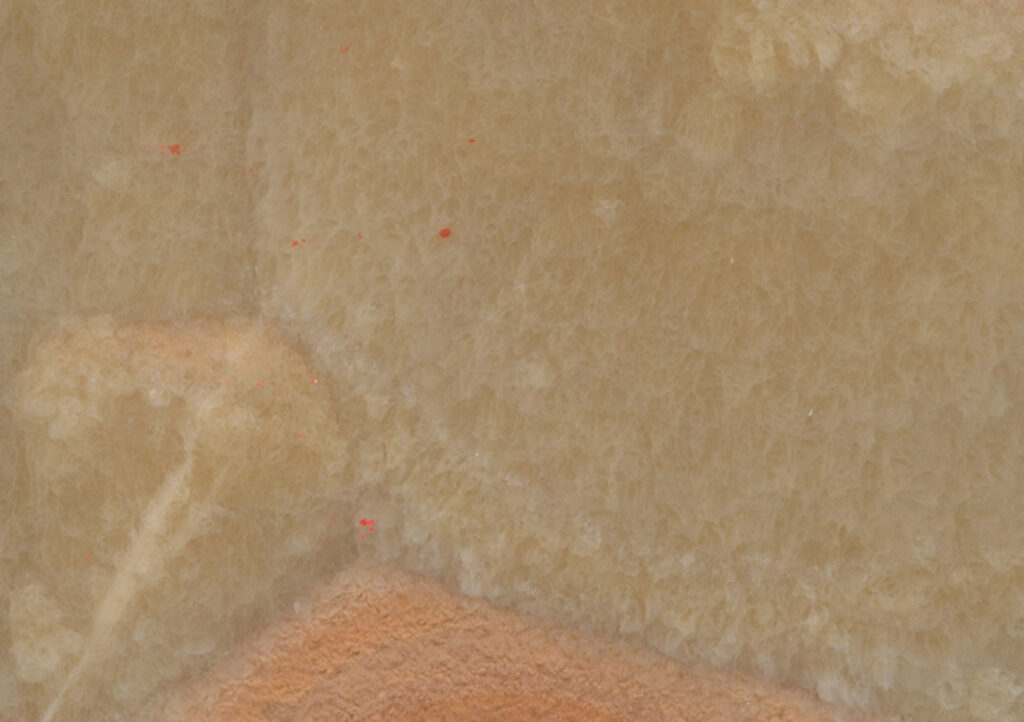
Onyx Miele al Contro

Onyx Miele al Contro
Náhľad materiálu:
Kontaktujte nás, radi Vám poradíme s výberom
Viac z tejto kategórie
Naši spokojní zákazníci
Dali sme si spraviť kamenný obklad na dom a dlažbu v záhrade. Od začiatku bola komunikácia jasná a bez zbytočných komplikácií. Všetko prebehlo podľa dohody, termíny sedeli a výsledok vyzerá presne tak, ako sme si predstavovali. Dom dostal úplne iný charakter a záhrada pôsobí oveľa upravenejšie.
Do kuchyne sme si vybrali pracovnú dosku a ostrov z Technistone a bola to výborná voľba. Materiál je príjemný na dotyk, pôsobí pevne a kvalitne a hlavne sa veľmi ľahko čistí, čo v kuchyni naozaj oceníte. Aj po čase používania vyzerá stále ako nový. S výsledkom sme maximálne spokojní.
Pre náš bar sme potrebovali niečo špeciálne, niečo, čo zapadne do celého konceptu a kameň bola naša prvá voľba. Zvolili sme Ónyx, ktorý prepúšťa svetlo a ktorý po nasvietení púta pozornosť každého zákazníka a dominuje celému priestoru. Spoluprácu s Kamene.sk môžem len odporúčiť.
Najčastejšie otázky
Aký materiál je najlepší na kuchynskú pracovnú dosku?
Na kuchynské pracovné dosky sa najčastejšie používa žula, ktorá je mimoriadne odolná voči poškodeniu, teplu aj vlhkosti. Je ideálna na každodenné používanie a má dlhú životnosť. Alternatívou môže byť aj technický kameň alebo mramor, ten je však náročnejší na údržbu.
Aký je rozdiel medzi žulou a mramorom?
Žula je tvrdší a odolnejší materiál vhodný aj do náročných podmienok, napríklad do kuchyne alebo exteriéru. Mramor je mäkší, má výraznejšiu kresbu a luxusný vzhľad, preto sa využíva najmä v interiéri.
Čo je technický kameň a aké má výhody?
Technický kameň je moderný materiál vyrobený z prírodných minerálov a živíc, ktorý vyniká vysokou odolnosťou a jednotným vzhľadom. Je menej nasiakavý ako prírodný kameň, ľahko sa udržiava a ponúka široký výber farieb a dekorov.
Je prírodný kameň vhodný do exteriéru?
Áno, prírodný kameň je vhodný aj do exteriéru, najmä žula a niektoré druhy travertínu. Tieto materiály sú odolné voči mrazu, vlhkosti a poveternostným vplyvom.
Je kameň náročný na údržbu?
Nie, údržba je jednoduchá. Stačí bežné čistenie a občasná impregnácia, ktorá ochráni povrch pred škvrnami a predĺži jeho životnosť.
Viete vyrobiť výrobky na mieru?
Áno, všetky kamenné produkty vyrábame na mieru podľa požiadaviek zákazníka. Zabezpečujeme zameranie, výrobu aj odbornú montáž.
Zabezpečujete aj zameranie a montáž?
Áno, poskytujeme kompletný servis od zamerania cez výrobu až po odbornú montáž. Vďaka tomu máte istotu, že všetko bude presne sedieť.
Ako prebieha objednávka a realizácia?
Proces začína konzultáciou a výberom materiálu, následne prebehne zameranie, cenová ponuka a výroba. Po dokončení zabezpečujeme aj profesionálnu montáž.
Ako dlho trvá výroba?
Doba výroby závisí od typu produktu a aktuálnej vyťaženosti, zvyčajne sa pohybuje v rozmedzí niekoľkých dní až týždňov. Presný termín vám radi upresníme po zameraní.
Aká je životnosť kamenných výrobkov?
Prírodný kameň má veľmi dlhú životnosť, často desiatky rokov. Pri správnej údržbe si zachová svoj vzhľad aj funkčnosť po veľmi dlhý čas.
Koľko stojí kamenná pracovná doska alebo obklad?
Cena závisí od výberu materiálu, rozmerov a náročnosti spracovania. Každý projekt pripravujeme individuálne, preto vám radi vypracujeme nezáväznú cenovú ponuku na mieru.